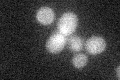
YDR411C
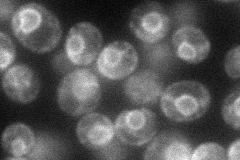
YDR411C
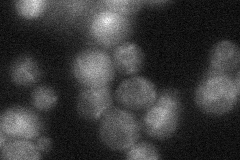
YDR411C

View description
ER localized derlin-like family member involved in ER stress and homeostasis; not involved in ERAD or substrate retrotranslocation; interacts with CDC48; contains four transmembrane domains and two SHP boxes
Localization:
Intensity:
Fold change:
Significance:
-
C’ GFP library in SD
below threshold15.96 -
N' NOP1pr-GFP in SD
ER57.285 -
N' TEF2pr-mCherry in SD

ER78.2256 -
N' NATIVEpr-GFP in SD
ER27.296 -
N' TEF2pr-VC and Cyto-VN in SD

below threshold22.2296 -
C’ GFP library in SD+DTT

cytosol18.491.15No -
C’ GFP library in SD+H2O2

cytosol16.871.05No -
C’ GFP library in Starvation Media

cytosol50.153.14No -
C’ GFP library on the background of Pup2-DaMP

below threshold -
C’ GFP library on the background of CCT mutant

below thresholdN/AN/ANo
